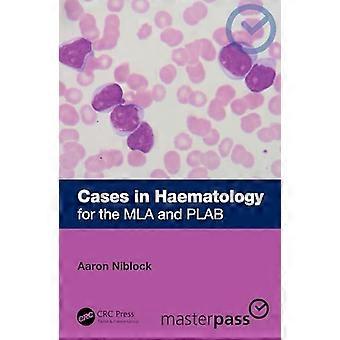

विज्ञान, चिकित्सा और प्रकृति
23,737 के सही मूल्य वाले विज्ञान, चिकित्सा और प्रकृति की सर्वोत्तम क़ीमत पर ख़रीदारी करें। Taylor & Francis Ltd, John Wiley & Sons Inc, John Wiley and Sons Ltd और बहुत कुछ पर बिक्री छूट, ऑफ़र और बचत के साथ, Fruugo के साथ विज्ञान, चिकित्सा और प्रकृति की खरीदारी करना आसान है। Fruugo के साथ सुरक्षित रूप से ऑनलाइन विज्ञान, चिकित्सा और प्रकृति खरीदें, सुरक्षित भुगतान और भारत में तेज़ शिपिंग के साथ।
फ़िल्टर
97 - 3,200 में से 128